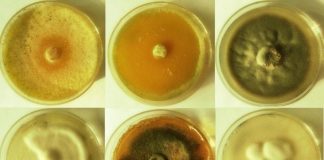
Фінські вчені створили яєчний білок з грибів, якими залатують тріщини в бетоні

NEWFOOD — це електронний журнал про foodtech. Про харчові технології майбутнього. На нашому сайті ви можете дізнатися про нові продукти харчування, продукти майбутнього, а також новини про здорову їжу, дієти, ресторани та інші заклади, корисні поради. Інтерв'ю з кращими шеф-кухарями, науковцями, рестораторами, дієтологами — все це ви можете прочитати на нашому сайті новин про їжу та продукти щодня.
Лист в редакцію: [email protected]